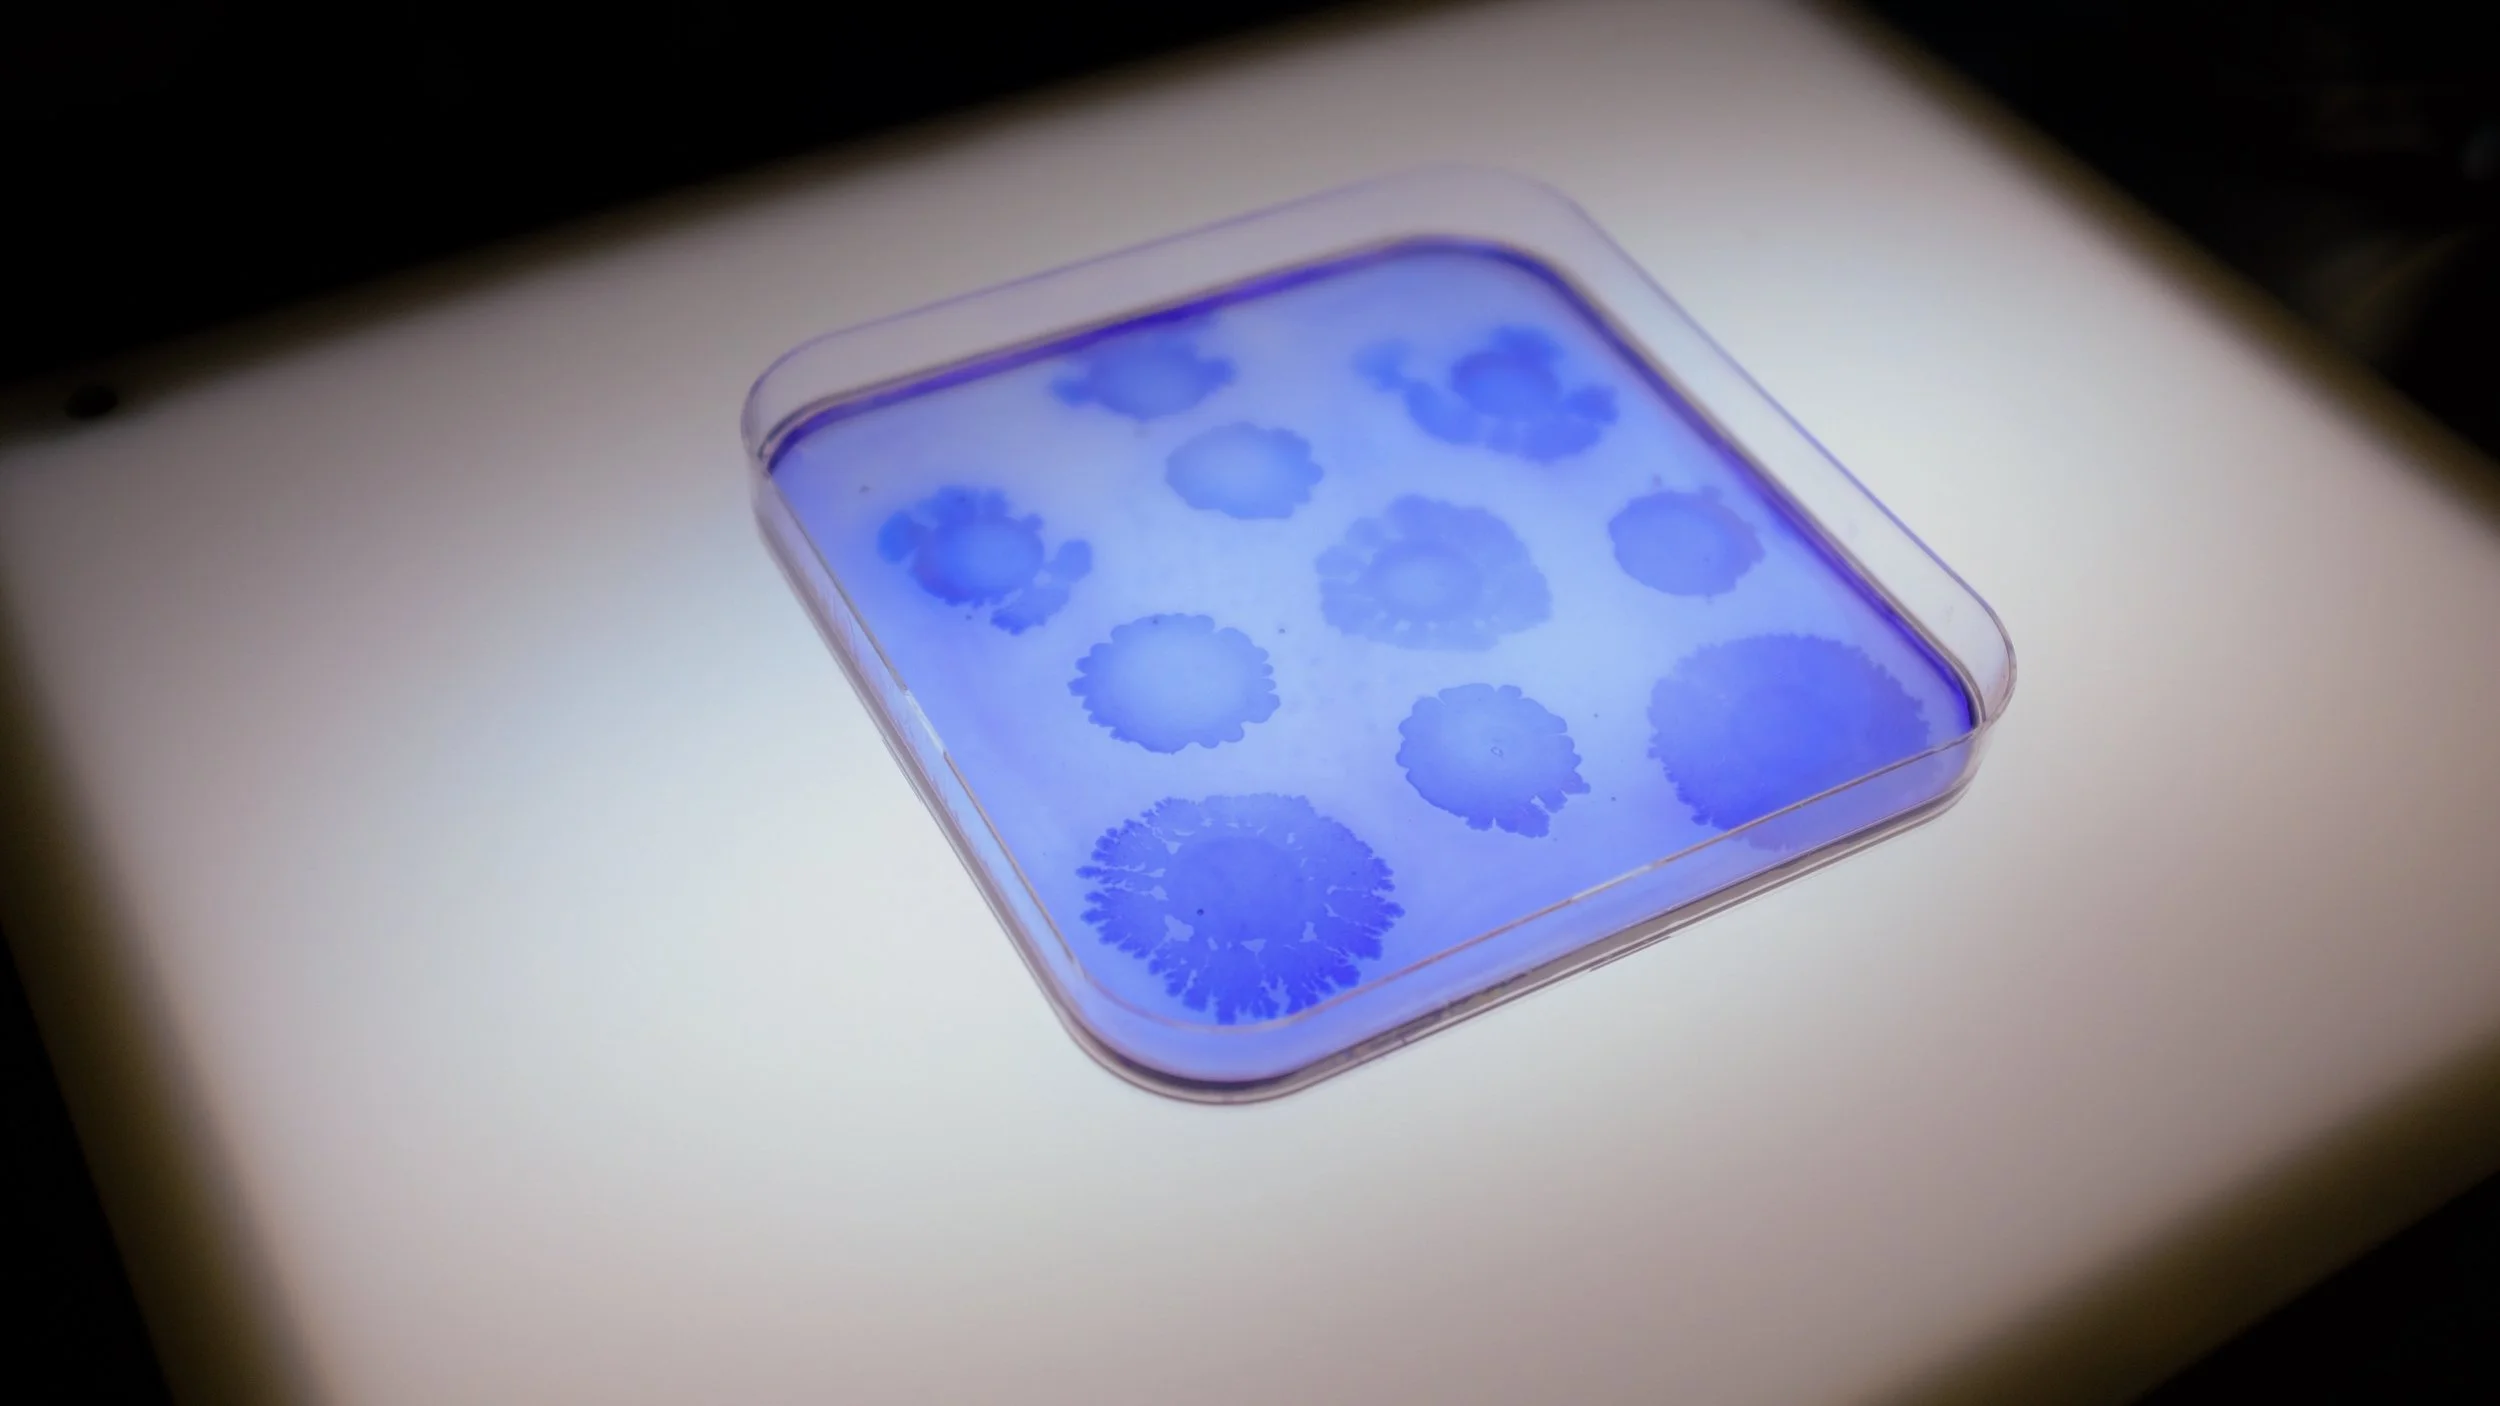
DSCF3297.jpeg
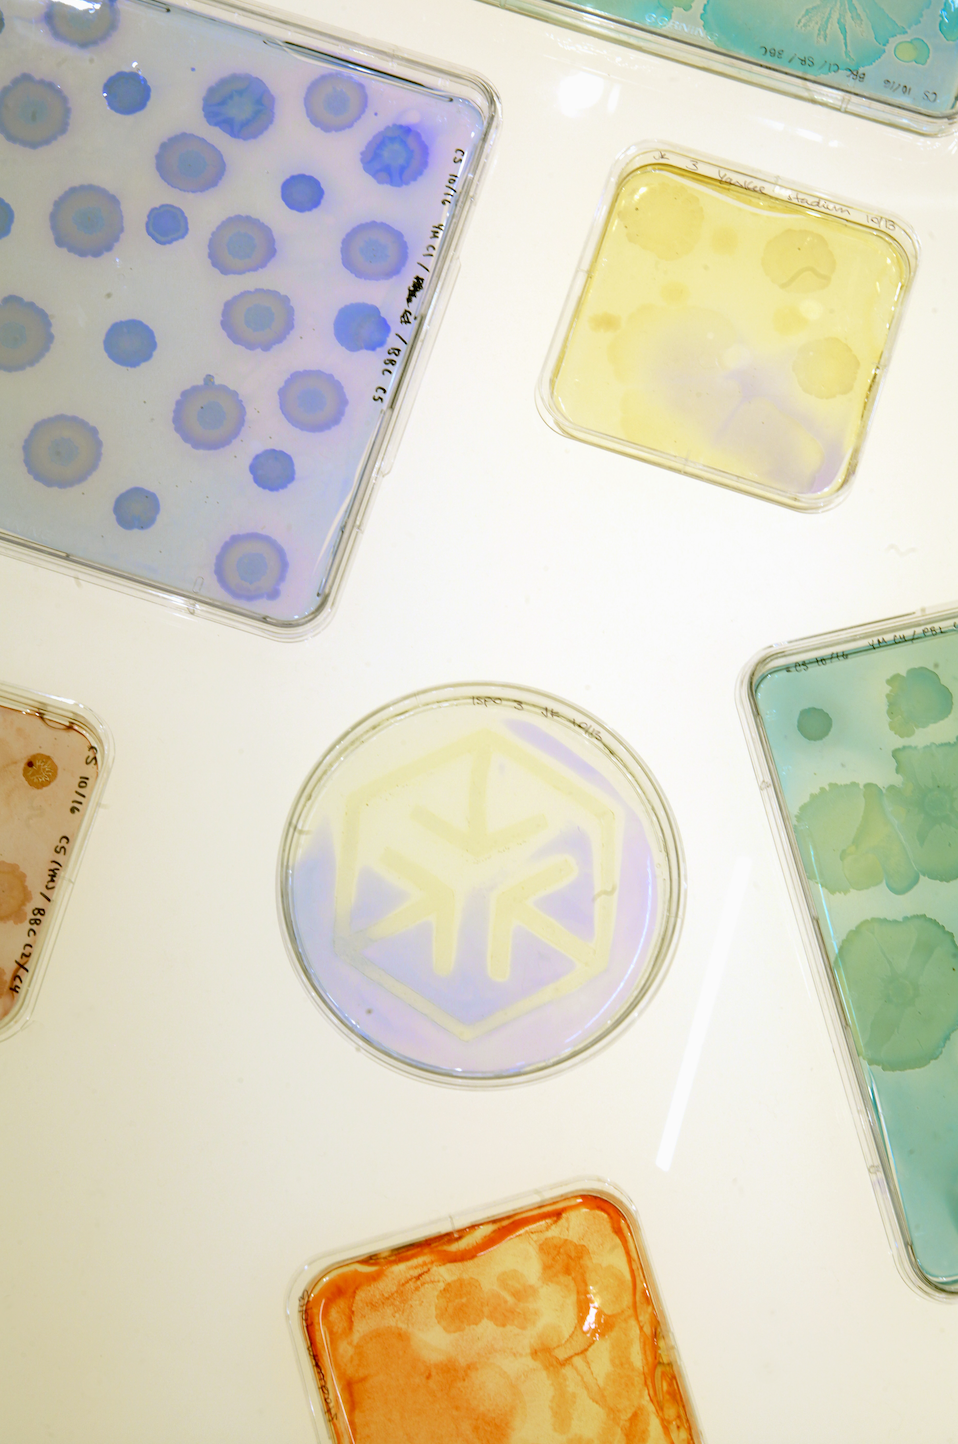
Screenshot 2025-12-18 at 2.38.52 PM.png
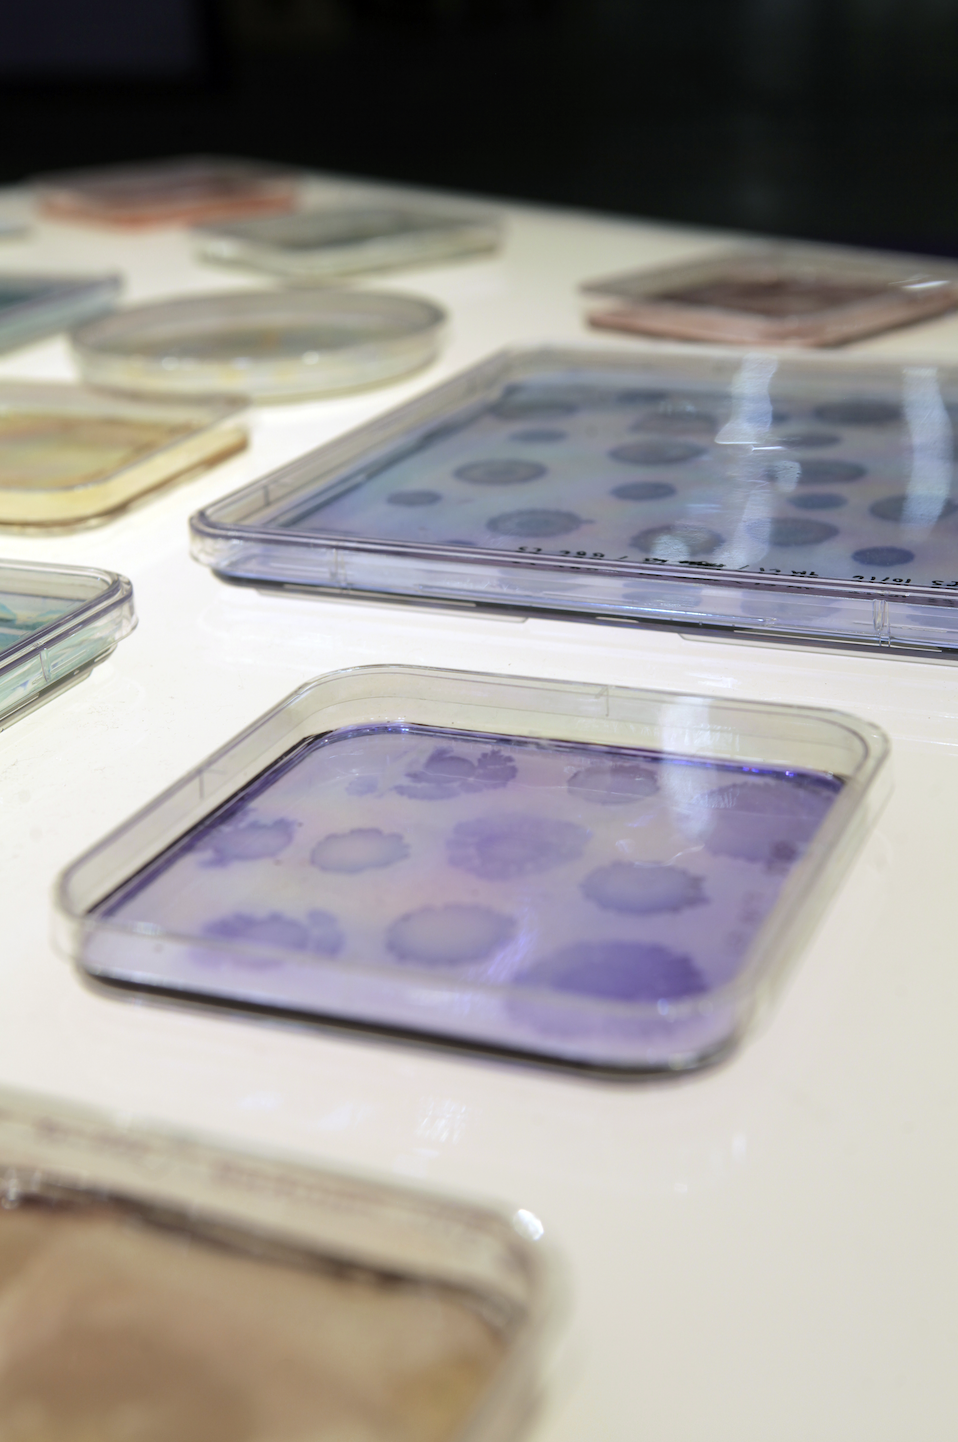
Screenshot 2025-12-18 at 2.39.08 PM.png

Microbial Arena, 2025
Bacteria were collected from swimming pools, tennis and basketball courts, baseball stadiums, and gyms across New York City, then cultivated on nutrient-rich agar to reveal their natural growth patterns. Some colonies spread and compete for space while others merge and cooperate — much like the teamwork and rivalry found in sports. Using chemical dyes, the distinct textures and shapes of each colony are brought to life in vivid, team-like colors. These forms reveal the hidden intelligence and beauty of microbial communities, reflecting the interplay of competition, cooperation, and adaptation that shapes life at both microbial and human scales.
The Microbial Arena was displayed as part of the Materials Lab at the 2025 ISPO Exhibition in Munich.